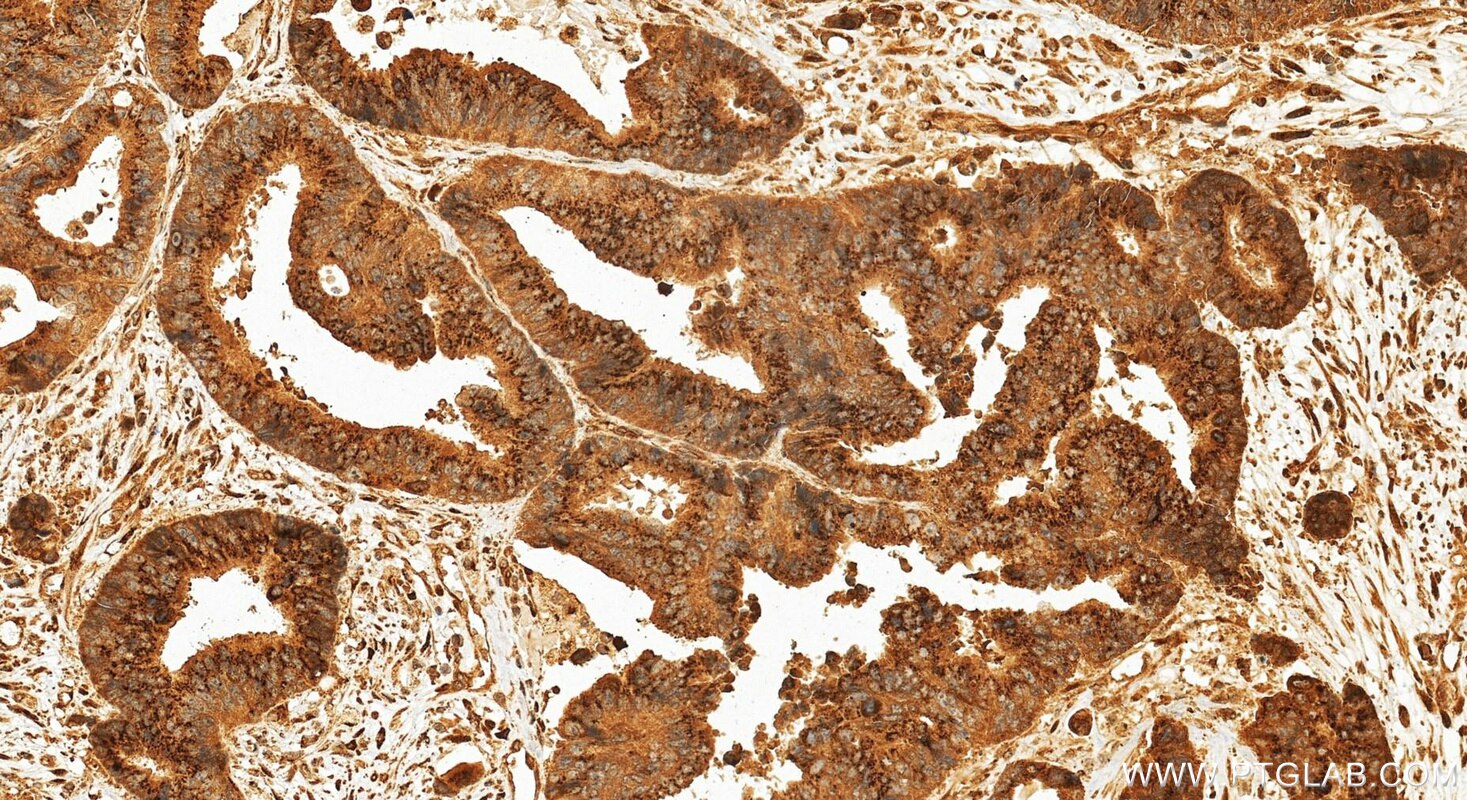
Immunohistochemical analysis of paraffin-embedded human colon cancer tissue slide using 27157-1-AP (ZFPL1 antibody) at dilution of 1:200 (under 20x lens). Heat mediated antigen retrieval with Tris-EDTA buffer (pH 9.0). Immunohistochemistry (IHC) staining of human colon cancer tissue using ZFPL1 Polyclonal antibody (27157-1-AP)

Tested Applications
| Positive WB detected in | HepG2 cells |
| Positive IHC detected in | human colon cancer tissue Note: suggested antigen retrieval with TE buffer pH 9.0; (*) Alternatively, antigen retrieval may be performed with citrate buffer pH 6.0 |
| Positive IF/ICC detected in | HepG2 cells |
Recommended dilution
| Application | Dilution |
|---|---|
| Western Blot (WB) | WB : 1:500-1:1000 |
| Immunohistochemistry (IHC) | IHC : 1:50-1:500 |
| Immunofluorescence (IF)/ICC | IF/ICC : 1:50-1:500 |
| It is recommended that this reagent should be titrated in each testing system to obtain optimal results. | |
| Sample-dependent, Check data in validation data gallery. | |
Product Information
27157-1-AP targets ZFPL1 in WB, IHC, IF/ICC, ELISA applications and shows reactivity with human samples.
| Tested Reactivity | human |
| Host / Isotype | Rabbit / IgG |
| Class | Polyclonal |
| Type | Antibody |
| Immunogen |
CatNo: Ag24097 Product name: Recombinant human ZFPL1 protein Source: e coli.-derived, PET28a Tag: 6*His Domain: 1-264 aa of BC012814 Sequence: MGLCKCPKRKVTNLFCFEHRVNVCEHCLVANHAKCIVQSYLQWLQDSDYNPNCRLCNIPLASRETTRLVCYDLFHWACLNERAAQLPRNTAPAGYQCPSCNGPIFPPTNLAGPVASALREKLATVNWARAGLGLPLIDEVVSPEPEPLNTSDFSDWSSFNASSTPGPEEVDSASAAPAFYSQAPRPPASPGRPEQHTVIHMGNPEPLTHAPRKVYDTRDDDRTPGLHGDCDDDKYRRRPALGWLARLLRSRAGSRKRPLTLLQR Predict reactive species |
| Full Name | zinc finger protein-like 1 |
| Observed Molecular Weight | 35-40 kDa |
| GenBank Accession Number | BC012814 |
| Gene Symbol | ZFPL1 |
| Gene ID (NCBI) | 7542 |
| RRID | AB_2880781 |
| Conjugate | Unconjugated |
| Form | Liquid |
| Purification Method | Antigen affinity purification |
| UNIPROT ID | O95159 |
| Storage Buffer | PBS with 0.02% sodium azide and 50% glycerol, pH 7.3. |
| Storage Conditions | Store at -20°C. Stable for one year after shipment. Aliquoting is unnecessary for -20oC storage. 20ul sizes contain 0.1% BSA. |
Background Information
The ZFPL1 protein is a zinc finger protein localized to the Golgi apparatus, and its function is closely associated with maintaining Golgi structural integrity. Research indicates that ZFPL1 interacts with the Golgi matrix protein GM130 through its N-terminal domain, and this interaction is crucial for the proper anchoring of GM130 to the Golgi. When ZFPL1 expression is suppressed, GM130 dissociates from the membrane, leading to the fragmentation of the Golgi ribbon structure and significantly impairing protein secretion and transport processes. Therefore, ZFPL1 is considered a key scaffolding protein essential for maintaining the normal structure and function of the Golgi apparatus. Currently, its specific role in highly polarized cells with active secretory functions, such as neurons, is a major focus in the field.
Protocols
| Product Specific Protocols | |
|---|---|
| IF protocol for ZFPL1 antibody 27157-1-AP | Download protocol |
| IHC protocol for ZFPL1 antibody 27157-1-AP | Download protocol |
| WB protocol for ZFPL1 antibody 27157-1-AP | Download protocol |
| Standard Protocols | |
|---|---|
| Click here to view our Standard Protocols |
Reviews
The reviews below have been submitted by verified Proteintech customers who received an incentive for providing their feedback.
FH Boyan (Verified Customer) (04-03-2024) | very good for IF; clear Golgi staining
|